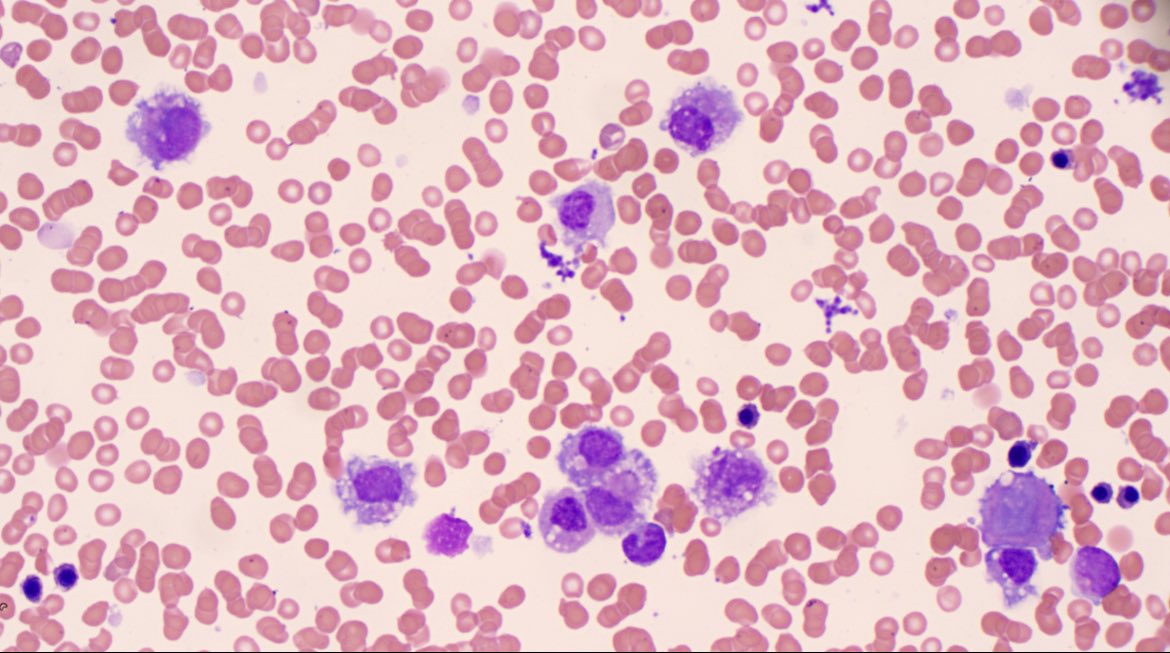

Kathryn Clarke
@kclarke864
Principal Clinical Scientist (Haemato-oncology), Belfast, Flow Cytometry.
ID: 961018211331342336
06-02-2018 23:26:11
278 Tweet
320 Takipçi
555 Takip Edilen

This year I will be taking part in a team relay in the Belfast City Marathon alongside my colleagues, to raise funds for Leukaemia&LymphomaNI 🏃♀️🩸 We have 4 teams made up of @BHSCT Scientists, Nurses and Medics We would be incredibly grateful for any donations!🤍 tinyurl.com/232bw5jj





Sharing this again with only 5 days to go. Help us reach our £2000 target. All donations are greatly appreciated 🩸 🔬 🩺 #beatingbloodcancerthroughresearch Laura Croan Anthony Abladey Jason Patterson Leukaemia&LymphomaNI

Delighted to be part of a great team running for Leukaemia&LymphomaNI in the BelfastCityMarathon Brilliant effort everyone! I’ll share the before photos only 😅 Anyone wishing to support a great charity link below. Kathryn Clarke Rich Gooding justgiving.com/page/bhsct-hae…


Thank you to everyone who donated. The 5 teams from BHSCT have raised £3900 and all had an amazing day at the BelfastCityMarathon 🩸 🔬 🩺 🏃♀️



Interested in how we use the #Amnis #ImageStreamX to assess cytogenetic abnormalities in #bloodcancer ? Jump on over to Cytek Biosciences to see our webinar. Feel free to message me if you have any questions, always happy to talk science 😆



Very proud of this lot representing the Haematology Laboratory Belfast Trust at this year’s Haematology Association of Ireland conference. Two great posters, two fantastic talks, one prize for best diagnostic laboratory presentation and a whole lot of memories made #HAI2024



The BURKITT Tour Ireland & UK 2025 Tickets: denisburkittfilm.com Culture_Ireland Irish Film Institute The MAC An Chultúrlann LDCRC University Of Limerick Nerve Centre NI Science Festival Film Hub NI Centre for Global Chronic Conditions, LSHTM Oxford Brookes Special Collections and Archive

We are delighted to announce the launch of the new LLNI Travel Support Fund which has been created to support the experts working in a haematology diagnostic laboratory. You can apply now at: llni.co.uk/our-research/l… If you would like more info please email [email protected]


A fantastic new initiative from Leukaemia&LymphomaNI to support those working in diagnostic haematology labs throughout NI. Belfast Trust Southern Trust South Eastern Trust Western Trust Northern Trust